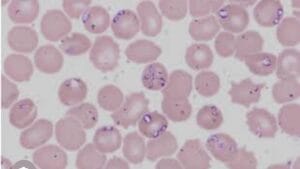

SERVICIILE NOASTRE
- Consultatii
- Tratamente
- Carnet de sanatate electronic - platforma INGIMED
- Vaccinari
- Deparazitari
- Microcipari
- Examen trichineloscopie
- Analize laborator (hematologie, biochimie, ex urnina, teste)
- Ecografie
- Radiologie digitala
- Anestezie inhalatorie
- Interventii chirurgicale
- Laserterapie
- Toaletare
- Diete veterinare, medicamente, hrana si accesorii
CONSULTATII SI TRATAMENTE
Consultația este primul pas și, probabil, cel mai important din parcursul terapeutic al pacientului.
Consultația include anamneza, acea parte în care proprietarul îi relatează medicului veterinar motivul pentru care s-a prezentat la cabinet. Aceste detalii ghidează medicul veterinar în alegerea investigațiilor care trebuie efectuate pentru a stabili un diagnostic de certitudine.
ECOGRAFIE
Cabinetul este dotat cu ecograf Mindray VETUS 50, având sondă microconvexă și sondă cardiacă Doppler.
Ecografia este o tehnică de investigare care utilizează ultrasunetele pentru vizualizarea în timp real a organelor și țesuturilor interne. Ultrasunetele sunt neinvazive și permit obținerea de imagini detaliate fără disconfort pentru pacient, fiind una dintre cele mai folosite metode imagistice în medicina veterinară.
Avantaje — nu doare, nu necesită în general sedarea animalului, permite vizualizarea organelor din cavitatea abdominală și toracică oferind informații prețioase privind forma, dimensiunea și structura lor, confirmă starea de gestație și posibilitatea examinării fetusilor și urmăririi evoluției sarcinii.
ANALIZE LABORATOR
ANALIZATOR SKYLA SOLUTION
- Biochimie
- Endocrinologie
- Imunologie
Skyla Solution este cel mai compact analizor de biochimie,endocrinologie,electroliti si imunologie,combina metode de imunoanaliza si biochimie intr-un singur dispozitiv pentru a oferi eficienta,accesibilitate si precizie.Rezultate obtinute pot fi integrate in aplicatia proprie si arhivate in fisa electronica pacientului
ANALIZATOR IMUNOFLUORESCENT VCHECK
Analize cantitative precise obtinute prin metode imunofluorescentei.Este posibila diagnosticarea unor afectiuni cum ar fi boli inflamatorii,pancreatita,afectiuni endocrine.
#CRP-proteina C reactiva,#SAA-amiloidul seric.#cPLlipaza specifica pancreatita canina,#fpl-lipaza specifica pancreatita felina,#cCortizol,#T$,TSH,#Progesteron,markeri cardiaci ==proBNP,#troponina
#Vcheck RDT-interpretare cantitativa teste rapide
RADIOLOGIE
Clinica Animal Doctor utilizeaza de aparatura de ultima generatie de
radiologie full digitala VETRX MEDICA.
Radiologia este o parte esentiala,non invaziva,a multor proceduri medicale la animale ,menite sa puna un diagnostic precis pentru foarte multe afectiuni.
Radiologia veterinara full digitala este utilizata pentru:
- confirmarea unor luxatii,fracturi sau alte afectiuni la nivelul oaselor, displazii de cot si sold
- evaluarea dimensiunii si formei unor organe
- demonstrarea prezentei unor corpuri straine
- demonstrarea acumularilor de lichid sau gaze
- confirmarea afectiunilor la nivelul coloanei-fracturi,hernii si alte afectiuni
CHIRURGIE
Efectuăm o gamă largă de intervenţii chirurgicale: sterilizări / castrări, intervenţii oncologice (cavitatea abdominală, la nivel cutanat, glanda mamară), intervenţii pe tubul digestiv (ocluzii, torsiuni gastrice), intervenţii pe aparatul urinar, cezariene etc. Ne asigurăm că fiecare procedură este efectuată cu grijă și în siguranță pentru patrupedul tău.
Sala noastră de chirurgie este dotată cu aparatură de ultimă generație: aparat de anestezie inhalatorie cu ventilator mecanic, concentrator de oxigen, monitorizare funcții vitale. Aceste echipamente ne permit să realizăm intervenții complicate la animale geriatrice sau intervenții care necesită anestezie de durată.
Anestezia generală implică riscuri, de aceea medicul poate recomanda investigații preoperatorii (analize de sânge, ecografie, radiografie, examen cardiologic) pentru siguranța pacientului. După intervenție, pacienții sunt monitorizați postoperator și primesc analgezice și tratamentul prescris pentru o recuperare rapidă și cât mai confortabilă.